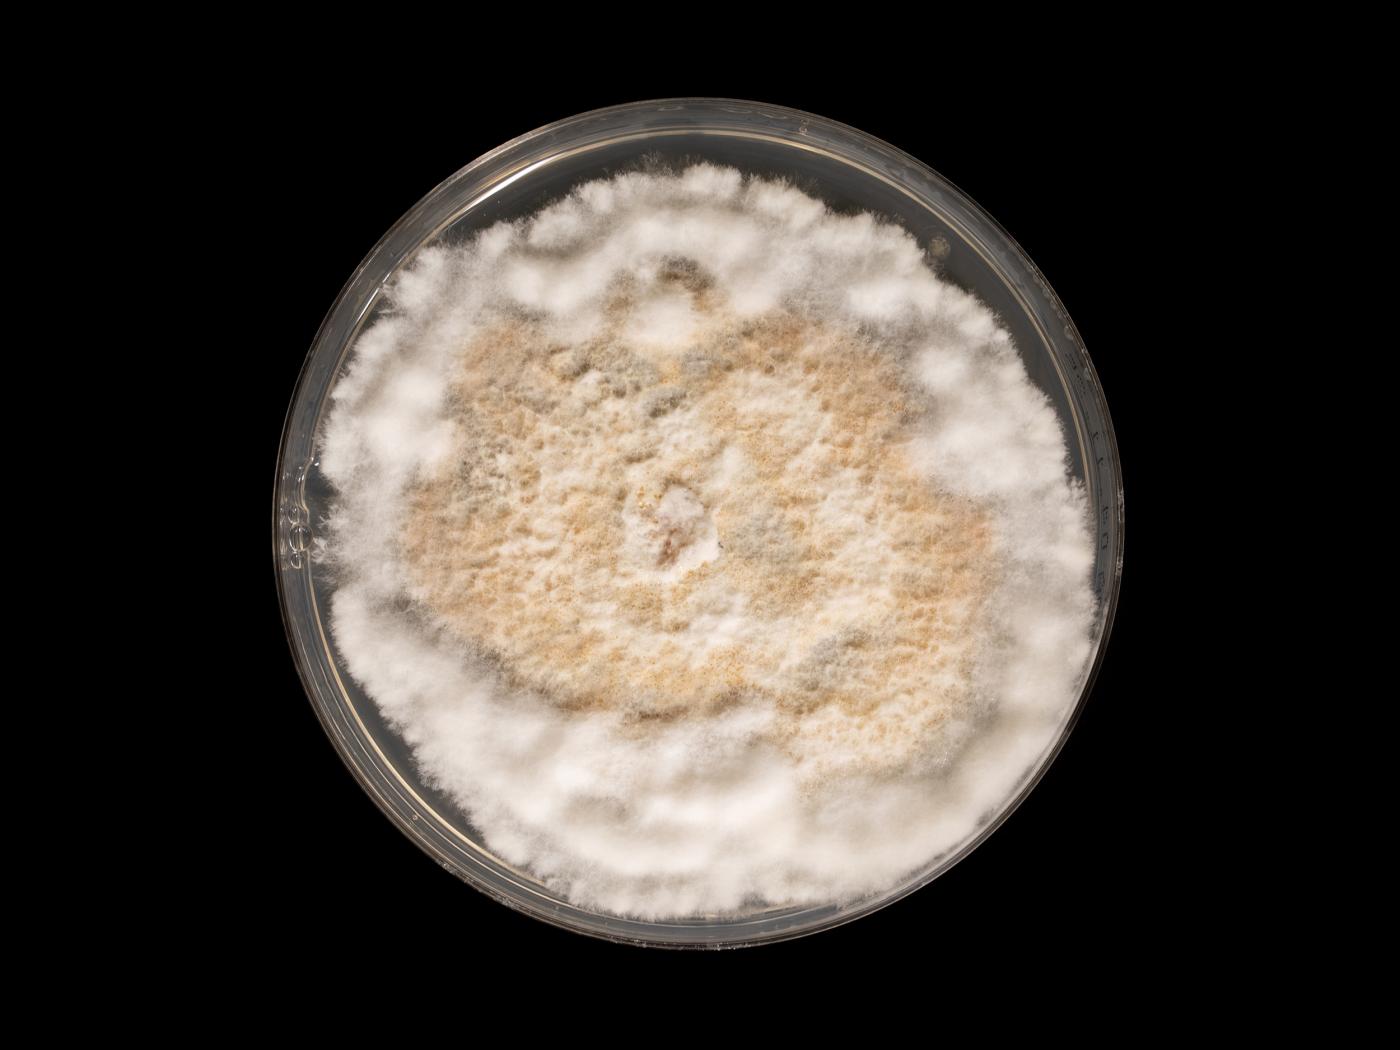

Nom latin :
Neopestalotiopsis sp.
Cultures ou autres organismes affectés
Fraise
/fr/maladies-parasitaires/champignons/neopestalotiopsis-sp/fraise-deperissement-neopestalotiopsien
Fraise - Dépérissement neopestalotiopsien (Neopestalotiopsis sp. )_1
Fraise - Dépérissement neopestalotiopsien (Neopestalotiopsis sp. )_2
Fraise - Dépérissement neopestalotiopsien (Neopestalotiopsis sp. )_3
Fraise - Dépérissement neopestalotiopsien (Neopestalotiopsis sp. )_4
Fraise - Dépérissement neopestalotiopsien (Neopestalotiopsis sp. )_5
Fraise - Dépérissement neopestalotiopsien (Neopestalotiopsis sp. )_2
Fraise - Dépérissement neopestalotiopsien (Neopestalotiopsis sp. )_3
Fraise - Dépérissement neopestalotiopsien (Neopestalotiopsis sp. )_4
Fraise - Dépérissement neopestalotiopsien (Neopestalotiopsis sp. )_5